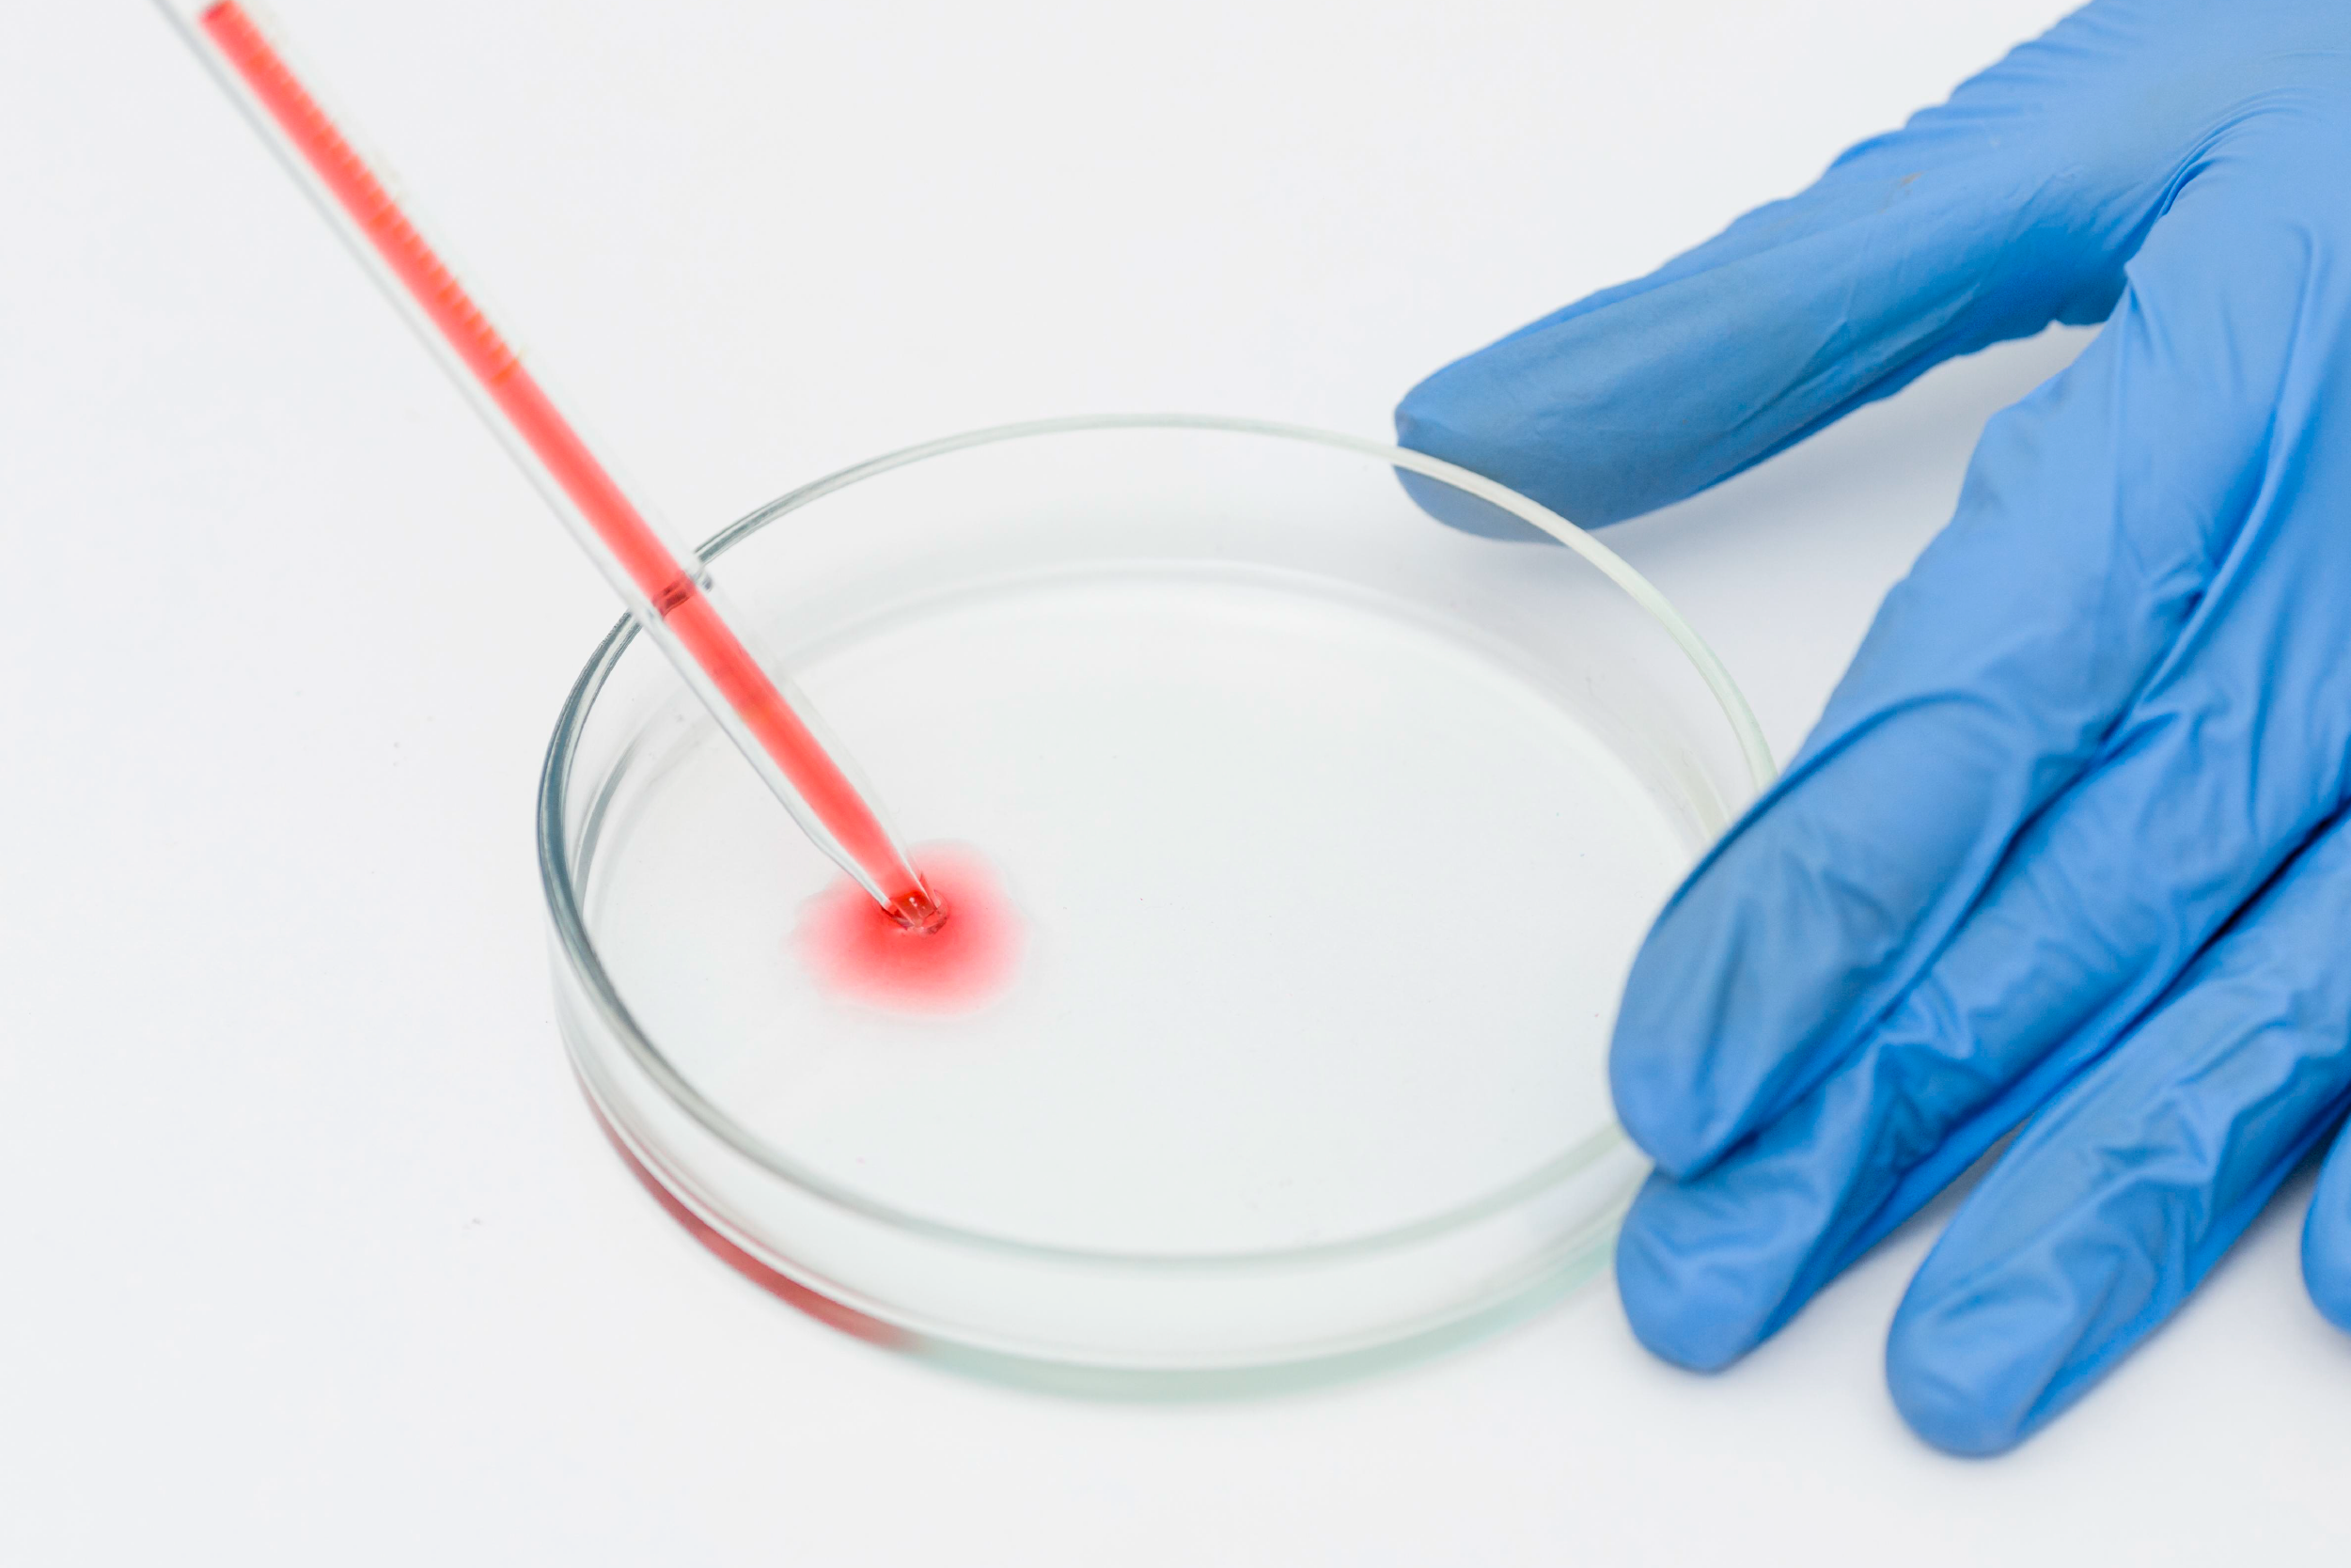

Sede Principal
Almagro 607 - Trujillo
informes@bermanlab.com
Horario de atención
Lunes - Domingo (24 Horas)
-
 ---Más información
---Más información -
 ---Más información
---Más información -
 ---Más información
---Más información
¿ PORQUÉ ELEGIR A
Bermanlab?
Somos un laboratorio dedicado a la prestación de servicios de análisis clínicos y anatomopatológicos, con más de 58 años de experiencia, brindando resultados confiables y oportunos siendo nuestra principal misión contribuir al diagnóstico clínico de nuestros pacientes con un compromiso profesional en todos los procedimientos.
Nuestras
Noticias

La inmunoglobulina E (IgE), es un tipo de anticuerpo que se encuentra principalmente en los pulmones, la piel y mucosas. juega un papel importante en la protección inmunológica frente
LEER MAS
El sistema del complemento está formado por una serie de proteínas que circulan en la sangre y ayudan al sistema inmunológico a combatir infecciones y eliminar células d
LEER MAS
¿Qué es?
Es una prueba de sangre moderna y precisa que detecta la infección por tuberculosis (TBC), incluso en su forma
LEER MAS
¿Qué es el Coombs Directo?
Es una prueba hematológica que detecta la presencia de anticuerpos adheridos a la superficie de los g
LEER MAS
Qué es la AMH?
La hormona antimulleriana (AMH) es una proteína producida por los ovarios en las mujeres y por los testículos en los homb
LEER MAS
¿Cuándo se realiza el análisis de Hemocultivo?
El hemocultivo se solicita cuando aparecen síntomas compatibles con sepsis, como:<
LEER MAS
¿Qué es?
La Beta 2-Microglobulina es una proteína presente en la superficie de todas las células nucleadas y en diversos fluidos del cuerpo, como
LEER MAS
¿Qué es y cuándo se realiza?
Este análisis es ideal para pacientes con diagnóstico presuntivo de infección urinaria que ya est&aacut
LEER MAS
El perfil cardíaco es una serie de pruebas de laboratorio que permiten evaluar la salud de tu corazón y detectar posibles problemas a tiempo. Incluye análisis
LEER MAS
¿Qué es la ferritina? La ferritina es una proteína esencial que almacena y libera hierro en el cuerpo. Se encuentra principalmente en el hígado, el bazo
LEER MAS
¿Qué son los reticulocitos? Los reticulocitos son precursores inmaduros de los glóbulos rojos y son esenciales para evaluar la actividad de la médula &o
LEER MAS
En BermanLab, comprendemos la importancia crítica de detectar bacterias resistentes a los antibióticos, especialmente aquellas productoras de carbapenemasas. Estos microorganismos rep
LEER MAS
La Somatomedina C, también conocida como IGF-1, es una proteína crucial producida principalmente en el hígado, que juega un papel vital en el crecimiento y la división c
LEER MAS
El análisis de gases arteriales es una herramienta esencial para evaluar la salud respiratoria, proporcionando información vital sobre los niveles de oxígeno, dióxido de
LEER MAS
El espermatograma es un análisis fundamental para evaluar la fertilidad masculina. En BermanLab, entendemos la importancia de este estudio y ofrecemos un servicio completo y confiable para b
LEER MAS
Estamos muy orgullosos de haber aprobado nuevamente el ISO 9001:2015. Esta certificación es un testimonio de nuestro compromiso con la excelencia en la gestión de calidad. Recuerda qu
LEER MAS
En BermanLab, entendemos la importancia de comprender a fondo tu salud metabólica. Es por eso que ofrecemos la prueba de Péptido C, una herramienta invaluable para evaluar la producci
LEER MAS
La vitamina D, esencial para la absorción de calcio y fósforo, es una aliada crucial para mantener huesos fuertes y prevenir la osteoporosis. Su papel en la regulación de la co
LEER MAS
La vitamina C, también conocida como ácido ascórbico, es un nutriente vital para nuestro bienestar. Más allá de su fama en la prevención de resfriados, des
LEER MAS
La prueba de Hemoglobina Glicosilada, también conocida como HbA1c, es un análisis que mide el porcentaje de hemoglobina recubierta de azúcar en los glóbulos rojos durant
LEER MAS
El Antifungigrama es una prueba microbiológica que mide la sensibilidad de un hongo a diferentes antifúngicos mediante el método de Microdifusión. Esta prueba brinda inf
LEER MASClientes Felices
Lo que nuestros pacientes dicen

Felicitaciones por la excelente atención, un saludo especial al doctor Berly Manrique.
Tere Gamarra de Barriga

Buen Laboratorio Bermanlab y la atención excelente, Dios los proteja aún más en estos momentos difíciles que estamos pasando. Bendiciones.
Roxana Garcia Bocanegra

Gracias por la atención q estan dando en este momento tan dificil q estamos pasando.
Gustavo Blas Rodriguez

Bermanlab hay buenos médicos a mí me atendió muy bien mis análisis me sacaron todo me salió bien buena atención.





